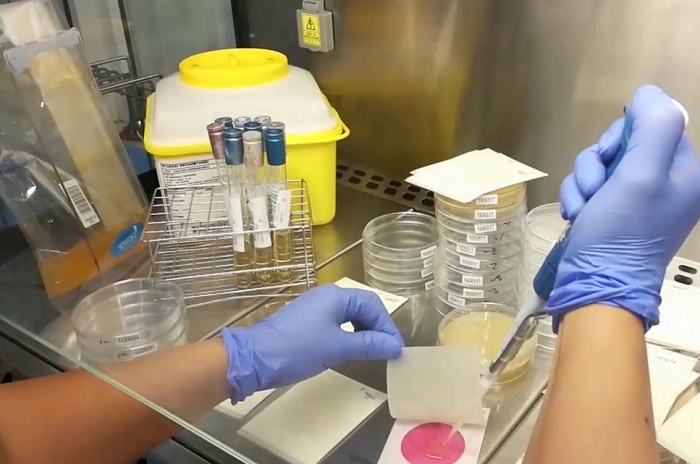

Análisis de Superficie
¿En qué consiste?
Se realiza análisis de superficies inertes en contacto con alimentos y bebidas según normativa nacional.
Ensayos microbiológicos
- Coliformes totales
- Staphylococcus aureus
- Salmonella spp.
- Listeria spp.
- Vibrio cholerae.
¿En qué te ayudamos?
Envíanos tus consultas. Nos encargaremos de comunicarnos para brindarte todo nuestro apoyo y nuestro mejor servicio.